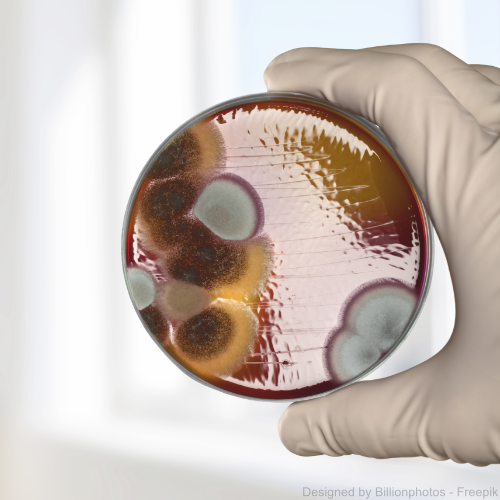

69,00 €
Sofort verfügbar, Lieferzeit: 1-3 Tage
✔️ Schimmelgattungen
✔️ Bei vermutetem Schimmelbefall
✔️ inkl. Abklatsch-Sammler
Produktinformationen "Schimmeltest Abklatsch"
Verdächtige Stelle auf Schimmel testen
Mit dem Schimmeltest Abklatsch lassen Sie eine Oberflächenprobe im Fachlabor auf Schimmel untersuchen. Der Abklatsch für die Probe kann von der Tapete, der Wand oder einer anderen Oberfläche genommen werden. Hierzu wird ein Nährboden auf die betroffene Stelle gedrückt, sodass mögliche Schimmelsporen aufgenommen werden.
Diese Sporen werden anschließend im Labor durch unsere Experten ausgewertet. Mit der Abklatsch Schimmelanalyse von Checknatura erhalten Sie einen zuverlässigen Nachweis darüber, ob auf der getesteten Oberfläche ein Schimmelbefall vorliegt. Außerdem werden im Labor die bei Ihnen auftretenden Schimmelpilzgattungen bestimmt. Dies kann bei der Eingrenzung möglicher Gesundheitsgefahren und bei der weiteren Vorgehensweise (z. B. Sanierung, Beseitigung von Wärmebrücken, Optimierung von Heiz- und Lüftungsverhalten) nützlich sein.

Ihre Vorteile
✅ Sehr einfache Probenahme mit unserem Test-Kit und der leicht verständlichen Anleitung
✅ Unkompliziert per Post versenden
✅ Untersuchung auf Schimmelsporen im Fachlabor
✅ Ergebnisbericht online abrufbar
✅ Leicht verständlicher Ergebnisbericht

Das ist im Preis enthalten
🧪 Anleitung zur Probenahme
🧪 Ein Nährboden für die Abklatschprobe
🧪 Laboranalyse Ihres Abklatsch Schimmeltests
🧪 Schutzbeutel und Schutzhandschuhe zur Probenahme
🧪 Probenbegleitschein und Test-Set-Box für den Rückversand
🧪 Leicht verständlich aufbereiteter Ergebnisbericht

Das wird untersucht
✔️ Anzahl der Schimmelsporen
✔️ Um welche Gattungen von Schimmelpilzen es sich handelt
✔️ Inklusive einer leicht verständlichen Erklärung zu den möglichen Gefahren durch die Schimmelpilze
So einfach funktioniert der Schimmeltest Abklatsch
Ihr persönliches Kundenportal
Sie erhalten den Prüfbericht in Ihrem sicheren Kundenportal MyChecknatura. Denn wir meinen: Ihre Umweltgesundheit geht nur Sie etwas an – ebenso wie Ihre personenbezogenen Daten.
Zudem erhalten Sie exklusiven Zugriff auf unsere Vergleichsfunktion. Dort können Sie die Ergebnisse Ihrer Analysen und einzelne untersuchte Parameter sogar über mehrere Jahre hinweg vergleichen, um Trends und Veränderungen zu visualisieren.

Unsere Checknatura-Expert:innen für Luftanalysen meinen
Das versprechen wir Ihnen:

Analyse im Qualitätslabor
Ihre Schimmelprobe wird in unserem Partnerlabor in Deutschland sorgfältig geprüft und ausgewertet. Das Labor arbeitet hierbei nach den höchsten Qualitätsstandards.

Leicht verständliches Ergebnis
Das Ergebnis der Analyse erhalten Sie als individuellen Bericht, in dem der Belastungsgrad sowie die jeweilige Schimmelpilzgattung verständlich erläutert werden.

Servicegarantie
Durch den TrustedShops-Käuferschutz und unsere Mitgliedschaft bei Verbraucherschutz.de stellen wir die Zufriedenheit unserer Kunden an erste Stelle.
Wenn es in der Wohnung muffig riecht oder sich bereits Flecken an Tapeten oder Möbeln abzeichnen, steht der Verdacht auf Schimmel schnell im Raum. Einige Pilzsporen bzw. Pilze, die in unserer Raumluft vorkommen oder sich auf Oberflächen ansiedeln, sind harmlos, andere können allerdings für Menschen und Tiere schädlich sein und unter anderem Reizungen von Atemwegen und Augen auslösen. Bei einer dauerhaften Schimmelbelastung kommt es durch chronische Atemwegsreizungen mitunter auch zur Ausbildung einer chronischen Bronchitis und Asthma. Bestimmte Stoffwechselprodukte, die von einigen Schimmelpilzarten gebildet werden, können zudem Allergien auslösen. Ein möglicher Schimmelbefall sollte daher schon aus Gründen des Gesundheitsschutzes immer ernst genommen werden. Zudem mindert natürlich der unangenehme Schimmelgeruch auch die Wohnqualität deutlich.
Mit dem Schimmel Abklatschtest von Checknatura gehen Sie auf Nummer sicher, was den eigenen Schimmelverdacht angeht. Sie erhalten Gewissheit darüber, ob ein Schimmelpilzbefall vorliegt und wenn ja, um welche Schimmelpilzgattung es sich handelt und welche Maßnahmen Sie weiterhin ergreifen können.
Genau erklärt: Von der Probenahme zum Ergebnis
- Bestellen Sie hier einfach und unkompliziert das Paket für die Testdurchführun Die Probenahme führen Sie selbst zu Hause durch.
- Lesen Sie sich dafür die Anleitung sorgfältig durch. Nehmen Sie die Probe mit Hilfe der beigefügten Handschuhe nach Anleitung und verstauen Sie die Probe sicher im Schutzbeutel.
- Füllen Sie die Informationen an das Labor gemäß der Anleitung aus und senden Sie Begleitschein und Nährboden im Test-Kit an unser Labor.
Nach Abschluss der Laboranalyse erhalten Sie von uns ein ausführliches Analyseergebnis. Selbstverständlich stehen wir Ihnen bei Rückfragen zum Ergebnis jederzeit über unseren freundlichen Kundenservice zur Verfügung.
Ist ein Test auf Schimmel auch ohne eine verdächtige Stelle für den Abklatsch möglich?
In diesem Fall empfehlen wir den Schimmeltest Raumluft, statt des Schimmeltests Abklatsch zu bestellen. Bei dem Schimmeltest Raumluft erhalten Sie von uns einen Nährboden, den Sie in Ihrem Zimmer aufstellen, damit die Schimmelsporen aus der Raumluft aufgenommen werden. Danach senden Sie diesen zurück an unser Labor und erhalten genaue Informationen zu dem Grad der Belastung, sowie den Gattungen von Schimmelpilzen, die sich in Ihrer Raumluft befinden.
Was ist der Unterschied zwischen einem Labortest und einem Schnelltest auf Schimmel?
Schimmel Schnelltests funktionieren im 1. Schritt ähnlich wie unsere Labortests: Sie entnehmen die Probe ebenfalls selbst oder stellen den Nährboden selber in Ihrer Wohnung auf. Der Unterschied liegt darin, dass Sie bei dem Schnelltest das Ergebnis selber ablesen und interpretieren müssen. Bei unserem Abklatschtest Schimmel wird hingegen der Nährboden von unserem Fachlabor untersucht und das Ergebnis interpretiert und einfach erklärt. Dadurch kann die Belastung genauer bestimmt werden und Sie erhalten zudem Informationen zu den entsprechenden Gattungen der Sporen und deren Gefahren.
Kann das Testergebnis für rechtliche Zwecke verwendet werden?
Leider ist eine Verwendung für rechtliche oder behördliche Zwecke meist nicht möglich. Der Grund dafür ist, dass Sie die Probe mit unserem Test selbst entnehmen und somit keine unabhängige Testung erfolgt ist. Sie wünschen eine unabhängige Schimmel-Probenahme? Kontaktieren Sie uns – wir vermitteln qualifizierte Fachkräfte!
Schimmel – unsere Top-Artikel
Gefahren: Wie gefährlich sind Schimmelpilze wirklich? Hier erfahren Sie es:
Schimmel: Gefahren, Nutzen, Vermeidung
Schimmel in der Schwangerschaft
Aus Versehen Schimmel gegessen?
Entfernen: Sie haben bereits Schimmel? Hier finden Sie unsere Schritt-für-Schritt-Anleitungen, wie Sie Schimmel auf der Wand und an anderen Stellen im Haus einfach mit Hausmitteln entfernen können:
Schimmel an der Wand entfernen
Schimmel aus Matratze entfernen
Schimmel im Kühlschrank entfernen
Schimmel in der Spülmaschine entfernen
Schimmel im Kleiderschrank entfernen
Schimmel aus Kleidung entfernen
Vermeiden: Erfahren Sie Tipps für die Vermeidung von Schimmel :
Schimmelarten: können in sämtlichen Farben und Formen auftreten. Erfahren Sie mehr zu den verschiedenen Schimmelarten:
Das Gewächshaus ist aufgrund der hohen Luftfeuchtigkeit besonders gefährdet. Mit ein paar einfachen Maßnahmen lassen sich jedoch Schädlinge und Schimmel einfach vermeiden:
Angaben zur Produktsicherheit:
Hersteller:
Reblu GmbH, Raiffeisenstr. 27-29, 70794 Filderstadt, Deutschland, www.reblu.de.
>> Sicherheitsdatenblatt zum Schimmeltest-Nährboden hier herunterladen